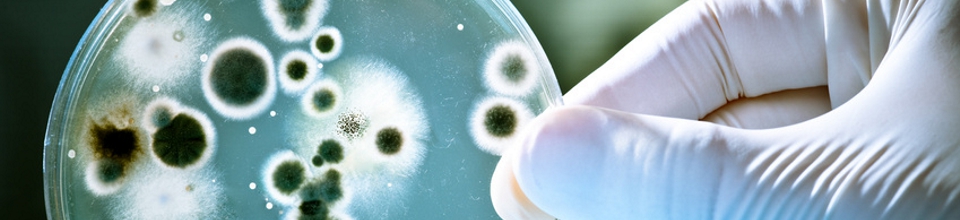

Dr. Kirchhoff
Wilhelmstraße 9
35781 Weilburg/Lahn
Tel: 06471-93720
Fax: 06471/937220
info@kirchhoff-anwalt.de
Notfallnummer: 0171/6252091
Wilhelmstraße 9
35781 Weilburg/Lahn
Tel: 06471-
info@kirchhoff-
Notfallnummer: 0171/6252091

Brennpunkt Herz-OP:
Indikation und Infektion




Kunstfehler-Prozesse






Ein Aufsatz von Dr. Burkhard
Kirchhoff, Dr. Matthias Thöns
und Andreas Herzig in:
Die Schwester/
Der Pfleger Heft 2/20
Kirchhoff, Dr. Matthias Thöns
und Andreas Herzig in:
Die Schwester/
Der Pfleger Heft 2/20


Deutsches Ärzteblatt 2/20
mit Einschätzungen von u.a.
Patientenanwalt Dr. Burkhard
Kirchhoff und namhaften
Hygiene-Experten.
Hier
mit Einschätzungen von u.a.
Patientenanwalt Dr. Burkhard
Kirchhoff und namhaften
Hygiene-

Zum Artikel -hier-






Patientenanwälte Dr.
Kirchhoff starten die
Kampagne "No Handshake"
zur Reduzierung der
Infektionszahlen.
Weitere Informationen
Kirchhoff starten die
Kampagne "No Handshake"
zur Reduzierung der
Infektionszahlen.
Weitere Informationen


